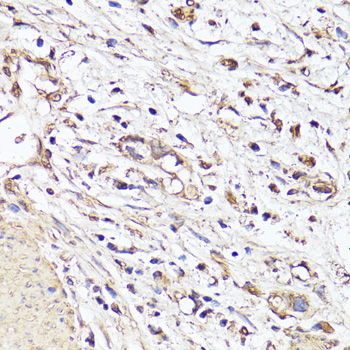

> Antigen, Antibodies, ELISA, Western Blot > Primary Antibody > Monoclonal Antibodies > VEGF Monoclonal AntibodyBrand |
Leading Biology | Catalog Number |
AMM08801N |
Product Type |
Monoclonal Antibodies | Field of Research |
Cardiovascular>Angiogenesis |
Product Overview |
We constantly strive to ensure we provide our customers with the best antibodies. As a result of this work we offer this antibody in purified format.
We are in the process of updating our datasheets. If you have any questions regarding this update, please feel free to contact our technical support team.
This product is a high quality VEGF Monoclonal Antibody.
|
||
Molecular Weight |
Calculated MW:
15-27kDa/34-45kDa
Observed MW:
Refer to figures
|
||
Species Reactivity |
Mouse
|
||
Immunogen |
Recombinant protein of human VEGFA
|
||
Cross Reactivity |
Human,Mouse,Rat
|
||
Isotype |
IgG
|
||
GeneID |
|||
UniProt ID |
|||
Purity |
Affinity purification |
||
Storage & Stability |
Store at +4°C short term. For long-term storage, aliquot and store at -20°C or below. Stable for 12 months at -20°C. Avoid repeated freeze-thaw cycles.
|
||
Storage Buffer |
Buffer: PBS with 50% glycerol, pH7.3.
|
||
Applications |
WB,IHC
|
||
Dilution |
IHC 1:50 - 1:200
|
||
Product Description |
This gene is a member of the PDGF/VEGF growth factor family. It encodes a heparin-binding protein, which exists as a disulfide-linked homodimer. This growth factor induces proliferation and migration of vascular endothelial cells, and is essential for both physiological and pathological angiogenesis. Disruption of this gene in mice resulted in abnormal embryonic blood vessel formation. This gene is upregulated in many known tumors and its expression is correlated with tumor stage and progression. Elevated levels of this protein are found in patients with POEMS syndrome, also known as Crow-Fukase syndrome. Allelic variants of this gene have been associated with microvascular complications of diabetes 1 (MVCD1) and atherosclerosis. Alternatively spliced transcript variants encoding different isoforms have been described. There is also evidence for alternative translation initiation from upstream non-AUG (CUG) codons resulting in additional isoforms. A recent study showed that a C-terminally extended isoform is produced by use of an alternative in-frame translation termination codon via a stop codon readthrough mechanism, and that this isoform is antiangiogenic. Expression of some isoforms derived from the AUG start codon is regulated by a small upstream open reading frame, which is located within an internal ribosome entry site.
|
||
Synonyms |
VEGFA; MVCD1; VEGF; VPF; vascular endothelial growth factor A
|
||
Images |

Immunohistochemistry of paraffin-embedded human colon using VEGFA antibody.
Immunohistochemistry of paraffin-embedded human stomach cancer using VEGFA antibody. |
||
Specification |
|||
Quantity |
|
||
| Select | Brand | Catalog No. | Product Name | Pack Size | Type | Field of Research | Specification | Quantity | Price(USD) | |
| 1 | Leading Biology | APG02467G | CCK4 / PTK7 Antibody (clone 4F9) | 50 μl | Monoclonal Antibodies |
|
$495.00 | Add Ask | ||
| 2 | Leading Biology | AMM04683G | GALT Antibody (clone 4C11) | 50 μg | Monoclonal Antibodies |
|
$545.00 | Add Ask | ||
| 3 | Leading Biology | AMM01402G | Vimentin (Mesenchymal Cell Marker) Antibody - With BSA and Azide | 50 ug | Monoclonal Antibodies |
|
$395.00 | Add Ask | ||
| 4 | Leading Biology | APR08280G | LTA4H / LTA4 Antibody (clone 9G8) | 50 μl | Monoclonal Antibodies |
|
$495.00 | Add Ask | ||
| 5 | Leading Biology | AMM00172G | CD1a / HTA1 (Mature Langerhans Cells Marker) Antibody - With BSA and Azide | 50 ug | Monoclonal Antibodies |
|
$395.00 | Add Ask | ||
| 6 | Leading Biology | AMM05750G | CEBPA Antibody | 100 μl | Monoclonal Antibodies |
|
$545.00 | Add Ask |
 Leading Biology Inc.
2600 Hilltop DR, Building G, B Suite C138
Richmond, CA, 94806
Tel: 1-661-524(LBI)-0262
Email: info@leadingbiology.com
Leading Biology Inc.
2600 Hilltop DR, Building G, B Suite C138
Richmond, CA, 94806
Tel: 1-661-524(LBI)-0262
Email: info@leadingbiology.com
Complete this form and click send to ask us a question, request a quote or simply say hello.

You have 0 item in your cart

You have 0 item in your inquiry list
